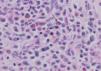

La hematopoyesis extramedular cutánea es una manifestación infrecuente de los procesos mieloproliferativos crónicos, principalmente de la mielofibrosis crónica idiopática. En el adulto se manifiesta como máculas, pápulas, nódulos y úlceras en el tronco. La aparición suele darse poco después del diagnóstico y todavía es una cuestión debatida la posible relación entre la esplenectomía y la aparición de los focos de hematopoyesis extramedular. El diagnóstico se realiza mediante estudio histopatológico y la visualización de un infiltrado compuesto por diferentes combinaciones de precursores mieloides, eritroides y células megacariocíticas. El tratamiento es sintomático y el propio de la enfermedad de base. Aportamos un nuevo caso asociado a mielofibrosis crónica idiopática que a los 9 años del diagnóstico presentó focos de hematopoyesis extramedular cutánea. Dichas lesiones siguieron un curso progresivo, desarrollando posteriormente una leucemia mieloide aguda.
Cutaneous extramedullary hematopoiesis is a rare manifestation of chronic myeloproliferative processes, mainly chronic idiopathic myelofibrosis. In adults, it manifests as macules, papules, nodules, and ulcers on the trunk. The lesions usually appear soon after diagnosis and the possibility of a relationship between splenectomy and the appearance of extramedullary foci of hematopoiesis is still debated. Diagnosis is based on histopathology showing an infiltrate with different combinations of myeloid and erythroid cell precursors and megakaryocytes. Symptomatic treatment is provided alongside treatment of the underlying disease. We report a new case associated with chronic idiopathic myelofibrosis in which foci of cutaneous extramedullary hematopoiesis were observed 9 years after initial diagnosis. The lesions were progressive and the patient went on to develop acute myeloid leukemia.
La hematopoyesis extramedular cutánea (HEC) se define como la presencia de elementos hematopoyéticos fuera de la médula ósea. Este proceso ocurre de forma fisiológica en embriones de 8 a 45cm1, siendo rara su manifestación después de este período. Se han descrito casos en neonatos en el contexto de infecciones intrauterinas y desórdenes hematológicos2. En adultos puede observarse asociado a síndromes mielodisplásicos y mieloproliferativos, es decir, a desórdenes en los que existe una hematopoyesis ineficaz o excesiva debido a la formación de un clon neoplásico derivado de una célula madre hematopoyética alterada3. Los procesos más frecuentemente asociados a la hematopoyesis extramedular cutánea son los síndromes mieloproliferativos crónicos, en concreto la mielofibrosis idiopática. De manera anecdótica se ha asociado a otras entidades como paquidermoperiostosis, pilomatrixomas, hemangiomas e incluso tras la inyección subcutánea de interleucina 33. Se presenta el caso de una paciente, con antecedentes de mielofibrosis idiopática, que tras 9 años de evolución desarrolló lesiones cutáneas compatibles histológicamente con focos de hematopoyesis extramedular cutánea.
Caso clínicoMujer de 55 años que consultó en noviembre de 2005 por la aparición de dos nódulos, uno en noviembre de 2004 en la región mamaria superior izquierda, y otro en octubre de 2005 en la región mamaria inferior. También refería la presencia de tres nódulos en el cuero cabelludo desde el 2002 por los que no había consultado previamente.
Entre sus antecedentes patológicos destacaba el diagnóstico de trombocitosis esencial en 1984 con posterior transformación a mielofibrosis idiopática en 1993. La paciente se mantuvo asintomática hasta que en 1998 desarrolló una esplenomegalia progresiva, requiriendo en 2001 una esplenectomía terapéutica y el inicio de tratamiento con hidroxiurea y posteriormente con anagrelide. Ambos fármacos se suspendieron por efectos secundarios y se mantuvo a la paciente con tratamiento sintomático y controles periódicos. En febrero de 2004 la enfermedad progresó y la biopsia de médula ósea mostró la transformación de la mielofibrosis idiopática a una leucemia mieloide aguda, por lo que se decidió iniciar tratamiento con 6-mercaptopurina.
A la exploración destacaba, en la región mamaria izquierda, la presencia de dos nódulos eritemato-violáceos, indurados, de 15 × 15mm (nódulo superior) y 10 × 8mm (nódulo inferior) (fig. 1). También se observaba presencia en cuero cabelludo de otros tres nódulos de similares características de 30, 20 y 10mm de tamaño respectivamente. (fig. 2).
Se realizó una biopsia de una lesión de la mama y de otra del cuero cabelludo. En ambas lesiones el estudio anatomopatológico fue similar, con la presencia de un denso infiltrado en dermis reticular compuesto por células mieloides en diferentes estadios de maduración y por megacariocitos. Se practicó un estudio inmunohistoquímico, observándose positividad para la mieloperoxidasa y para el CD68. El número de células CD34 positivas no fue significativo. Estos hallazgos fueron compatibles con el nuestro de hematopoyesis extramedular cutánea (figs. 3, 4 y 5).
En una analítica reciente destacaba una hemoglobina de 90g/l, plaquetas 165 × 10 E9/l y leucocitos 8,48 × 10 E9/l (5 % blastos, 57 % neutrófilos, 16 % linfocitos, 1 % eosinófilos y basófilos, 12 % leucoblastos, 2 % mielocitos y 2 % metamielocitos).
Dada la lenta progresión de las lesiones y la falta de sintomatología acompañante se optó por una actitud expectante. Las lesiones han permanecido estables hasta el momento actual.
DiscusiónLa mielofibrosis idiopática se caracteriza por la proliferación de células endoteliales y fibroblastos en la médula ósea4, lo cual provoca la disrupción de la barrera entre la médula ósea y la sangre periférica con la posterior migración y proliferación de células madre hematopoyéticas en otros órganos3.
La hematopoyesis extramedular en el contexto de una mielofibrosis idiopática fue descrita por primera vez por Hickling en 1937 citado por Kuo et al5. En la mayoría de casos reportados los focos de hematopoyesis extramedular se localizan en bazo e hígado. Otras localizaciones incluyen ganglios, retroperitoneo, columna vertebral, riñones, glándulas suprarrenales, tracto gastro-intestinal, pulmón y mamas. La afectación de la piel es rara y la de otros órganos como los testículos es excepcional6. El hecho de que se afecten más frecuentemente unos órganos que otros puede deberse a la predilección de las células madre hematopoyéticas por implantarse en órganos ya predispuestos a la hematopoyesis, como lo serían el bazo o el hígado. Recientemente se ha realizado una revisión de 510 casos de pacientes con hematopoyesis extramedular, observándose que en sólo 27 de los 510 casos los focos de hematopoyesis no eran hepatoesplénicos y que 18 de los 27 casos eran secundarios a mielofibrosis crónica idiopática de base7.
La afectación de la piel es infrecuente y se ha estimado una prevalencia del 0,4 % de los casos8. Se cree que la esplenectomía podría actuar como un factor predisponente en la siembra de focos de hematopoyesis extramedular en la piel, bien sea a través del arrastre mecánico presente durante el acto quirúrgico8,9, bien mediante la expansión de estos focos de hematopoyesis del bazo a otros órganos, como el hígado o la piel10. La relación entre la esplenectomía y la hematopoyesis en la piel sigue estando en discusión, ya que si bien hay casos descritos, en la mayoría o no existía el antecedente de esplenectomía previa1-3,6,11, o el período entre ésta y la aparición del foco de hematopoyesis en la piel era demasiado prolongado12,13. Las lesiones cutáneas pueden manifestarse de forma muy variada, como máculas, pápulas, nódulos e incluso como úlceras5. Hay casos descritos de lesiones cutáneas tipo angioma14 y otros con formación de ampollas y hemorragias10. La localización más frecuente en el adulto es el tórax y el abdomen y en el niño la cabeza y el cuello2. En la mayoría de casos descritos las lesiones suelen ser múltiples, en número superior a 109,11-13,15, habiéndose reportado casos aislados con más de 50 lesiones1. El diámetro oscila entre 0,5cm y 5cm9,10,12,13, aunque se ha descrito algún caso con un tamaño superior a 10cm8. No se ha encontrado relación entre el grado de fibrosis de la médula ósea y la extensión de las lesiones cutáneas de hematopoyesis extramedular15.
En la mayoría de los casos las lesiones suelen aparecer en el intervalo de un año tras el diagnóstico de la mielofibrosis, aunque se ha publicado algún caso aislado en el que las lesiones de la piel han aparecido hasta 8 años después14, o en el que la enfermedad ha comenzado junto a las lesiones cutáneas10,16.
Histológicamente se caracteriza por un infiltrado dérmico de aspecto polimorfo, compuesto por una combinación de precursores mieloides, eritroides y megacariocitos13. En una revisión de casos de hematopoyesis extramedular cutánea, realizada por Mizoguchi et al10, encontraron que en un número elevado de casos sólo existían precursores de dos o de una serie hematopoyética. En los niños con frecuencia existe un predominio de los precursores eritroides, y los megacariocitos suelen estar ausentes, mientras que en los adultos suelen predominar los megacariocitos2. Sólo la mitad de los casos con hematopoyesis extramedular cutánea en adultos muestran precursores eritroides en la biopsia2. A través de estudios inmunohistoquímicos se han observado reacciones positivas para mieloperoxidasa (serie mieloide) y para el factor de von Willebrand (serie megacariocítica). La mayoría de células precursoras mieloides eran únicamente positivas para mieloperoxidasa, confirmando su estirpe granulocítica. Sólo en una minoría de células se observó positividad para el CD68, el cual es expresado tanto en células granulocíticas maduras e inmaduras como en monocitos y macrófagos16. En un caso publicado por Kwon et al se observó un gran número de precursores eosinofílicos, siendo su significado desconocido hasta el momento11.
El diagnóstico diferencial principal se debe realizar con la leucemia cutis, ya que en un 8 % de los casos se ha descrito una evolución de la mielofibrosis crónica idiopática a una leucemia mieloide aguda9,17. En el caso que nos ocupa existía, en el momento de las biopsias, una leucemia mieloide aguda establecida. Cabría pensar si el infiltrado cutáneo no es en realidad una infiltración leucémica. La larga evolución previa de las lesiones y las características histológicas del infiltrado no apoyan este diagnóstico. En un infiltrado leucémico esperaríamos mayor monomorfismo y densidad celular, así como un mayor número de células CD34.
Se han descrito casos de fallecimiento por transformación leucémica de la enfermedad15, sobre todo en los que se encontraban megacariocitos atípicos5.
Se recomienda el tratamiento de los focos de hematopoyesis extramedular cutánea si las lesiones cutáneas son sintomáticas o por su localización o extensión, o en casos en los que la enfermedad de base requiera tratamiento sistémico. Se han publicado respuestas de las lesiones cutáneas tras el tratamiento de la enfermedad de base con hidroxiurea8,15 y con interferón alfa16, aunque en ambas modalidades existen fracasos terapéuticos13. Se han publicado casos de lesiones cutáneas tratadas con haz de electrones con buena respuesta clínica5,8.
En nuestro caso queremos destacar la aparición de focos de hematopoyesis extramedular cutánea 9 años tras el diagnóstico de la mielofibrosis idiopática, y el desarrollo de nuevos focos después de la transformación leucémica de la enfermedad.
Conflicto de interesesDeclaramos no tener ningún conflicto de intereses.